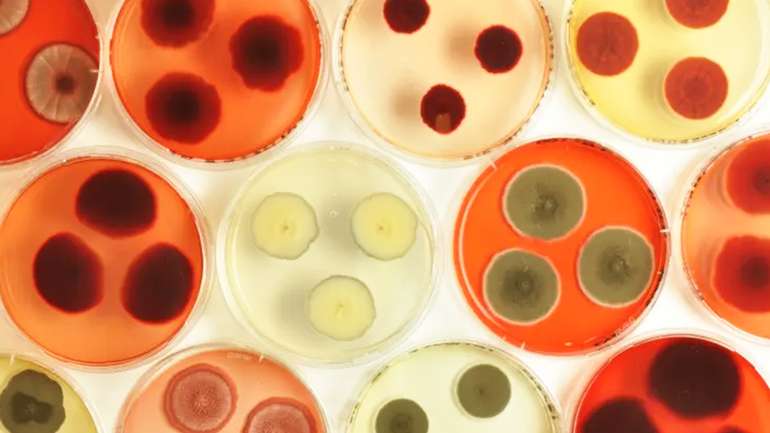

«Риба з біореактора»: вчені взялися створювати штучні морепродукти
Збільшення кількості людей на планеті призводить до зменшення їжі та води, а неефективне використання ресурсів пришвидшує зміни клімату.
До такого висновку прийшли деякі європейські вчені, котрі аґітують вирощувати рибу у пробірках, аби "нагодувати всіх нужденних", інформує видання "Forbes".
Вказану ініціативу вже підхопили різні так звані "еколоґічні стартапи" по всьому світу, зокрема у США, де є необхідні умови для виробництва морепродуктів із біореактора.
Однак при цьому ні науковці, ні борці з ґлобальним потеплінням навіть не намагаються пояснити всі "плюси" та "мінуси" від вживання ерзац риби.
Прикметно, що аквакультури (різні види морепродуктів) — справжній продовольчий резерв людства, якого вдосталь у світовому океані.
Скажімо, ферми мідій тисячами з'являються у різних країнах, адже мушля росте без всякої підгодівлі, на природних ресурсах морської води.
Між тим, як раніше вже повідомляв "Останній Бастіон", сумнівна американська "курятина з пробірки" уже виходить на міжнародний ринок.